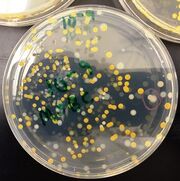
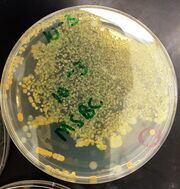

Uploads by Megan Stocking
From OpenWetWare
Jump to navigationJump to search
This special page shows all uploaded files.
| Date | Name | Thumbnail | Size | Description |
|---|---|---|---|---|
| 20:34, 28 July 2014 | Bacteria diagram.png (file) |  |
25 KB | bacteria table |
| 02:36, 17 July 2014 | Inverts table.png (file) |  |
17 KB | inverts mstocking |
| 02:36, 17 July 2014 | Flea.jpg (file) |  |
32 KB | flea2 mstocking |
| 01:26, 17 July 2014 | Sucking lice.jpg (file) |  |
34 KB | lice mstocking |
| 01:26, 17 July 2014 | Millipede.jpg (file) |  |
36 KB | millpede mstocking |
| 01:26, 17 July 2014 | Termite.png (file) |  |
9 KB | termite mstocking |
| 00:08, 15 July 2014 | Plant table A.png (file) |  |
46 KB | plant table mstocking |
| 23:23, 13 July 2014 | Fern.jpg (file) |  |
48 KB | fern image mstocking |
| 23:23, 13 July 2014 | Angiosperm 4.jpg (file) |  |
72 KB | pink flower image mstocking |
| 23:23, 13 July 2014 | White flower.jpg (file) |  |
41 KB | white flower image mstocking |
| 23:23, 13 July 2014 | White berry.jpg (file) |  |
47 KB | white berry image mstocking |
| 23:23, 13 July 2014 | Grass.jpg (file) |  |
61 KB | grass image mstocking |
| 03:33, 10 July 2014 | Serial dilutions table.png (file) |  |
9 KB | serial dilutions table |
| 01:31, 10 July 2014 | Bacteria charact.png (file) |  |
32 KB | bacteria charact mstocking |
| 01:31, 10 July 2014 | Colony C.jpg (file) |  |
64 KB | colony c picture |
| 01:15, 10 July 2014 | Colony B.jpg (file) | |
60 KB | colony b picture mstocking |
| 01:15, 10 July 2014 | Colony A.jpg (file) | |
59 KB | colony a picture mstocking |
| 01:15, 10 July 2014 | 10 nine tetra.png (file) |  |
11 KB | colony b drawing mstocking |
| 01:15, 10 July 2014 | 10 nine nutrient.png (file) |  |
13 KB | colony c drawing |
| 01:15, 10 July 2014 | 10 thirs nutrient.png (file) |  |
13 KB | colony a drawing mstocking |
| 21:29, 9 July 2014 | Serial dilution diagram.png (file) |  |
15 KB | Serial dilutions mstocking |
| 02:48, 8 July 2014 | Bio life.png (file) |  |
288 KB | abiotic and biotic |
| 21:04, 7 July 2014 | Stentor.png (file) |  |
15 KB | Stentor, Bottom Niche, Wet Mount #4 |
| 21:04, 7 July 2014 | Pandorina.png (file) |  |
7 KB | Pandorina, Top Niche, Wet Mount #2 |
| 21:04, 7 July 2014 | Arcella.png (file) |  |
6 KB | Arcella, Bottom Niche, Wet Mount #3 |
| 21:04, 7 July 2014 | Gonium.png (file) |  |
7 KB | Gonium, Top Niche, Wet Mount #1 |
| 21:04, 7 July 2014 | Bottom niche.jpg (file) |  |
34 KB | Bottom Niche |
| 21:02, 7 July 2014 | Top niche growth.jpg (file) |  |
57 KB | Top Niche |
| 21:02, 7 July 2014 | Hay infusion.jpg (file) |  |
45 KB | Hay Infusion Culture |
| 22:20, 5 July 2014 | Mini marsh.png (file) |  |
373 KB | Mini Marsh Images |
| 22:07, 5 July 2014 | Mini Marsh Aerial View Main.pdf (file) | 239 KB | Mini Marsh Images | |
| 21:35, 5 July 2014 | Mini marsh aerial-right2 mstocking.jpg (file) |  |
96 KB | Mini Marsh Aerial View Right |
| 21:35, 5 July 2014 | Mini marsh aerial-left2 mstocking.jpg (file) |  |
100 KB | Mini Marsh Aerial View Left |
| 21:35, 5 July 2014 | Mini marsh aerial view2 mstocking.jpg (file) |  |
145 KB | Mini Marsh Aerial View Main-Center |
| 21:23, 5 July 2014 | Mini marsh aerial view mstocking.jpg (file) |  |
1.75 MB | Mini Marsh Aerial View Main-Center |
| 21:22, 5 July 2014 | Mini marsh aerial-right mstocking.jpg (file) |  |
959 KB | Mini Marsh Aerial View Right |
| 21:22, 5 July 2014 | Mini marsh aerial-left mstocking.jpg (file) |  |
985 KB | Mini Marsh Aerial View Left |
| 21:06, 5 July 2014 | Mini marsh aerial view center mstocking.jpg (file) |  |
1.75 MB | Transect #1 Aerial View Center |